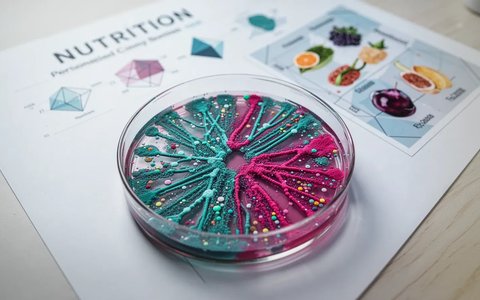
Darm-Mikrobiom ersetzt pauschale Diäten bei Reizdarm - Foto: über boerse-global.de

Thema: Darm-Mikrobiom
Darm-Mikrobiom, Bakterienarten

Mikroskopische Ansicht verschiedener Darmbakterien, abstrakt leuchtend mit subtilen Farb- und Formunterschieden. - Foto: über boerse-global.de

Darm-Mikrobiom: 176 Bakterienarten zeigen Parkinson Jahre voraus
boerse-global.de, 13.06.26 04:39 Uhr
Demenz-Früherkennung, Bluttest
Aktuelle Forschung zeigt: Darm-Mikrobiom beeinflusst Demenz-Früherkennung ...
Demenz-Früherkennung: Bluttest identifiziert Abbau 79% genau
boerse-global.de, 09.06.26 08:29 Uhr
Darm-Mikrobiom, Fasten
Eine Studie zeigt dass Fasten die Wirksamkeit von Opioiden ...
Darm-Mikrobiom: Fasten revolutioniert Schmerztherapie
boerse-global.de, 20.04.26 09:09 Uhr
Darmflora, Wirkung
Die gesundheitliche Wirkung von Polyphenolen hängt nicht ...
Darmflora entscheidet über Wirkung von Polyphenolen
boerse-global.de, 11.04.26 20:11 Uhr
Darm-Mikrobiom, Schaltzentrale
Die Darmgesundheit und Mikronährstoffe sind entscheidend ...
Darm-Mikrobiom: Die geheime Schaltzentrale unseres Immunsystems
boerse-global.de, 24.03.26 00:00 Uhr
Ernährung, Krankheitsrisiko
Die Ernährung beeinflusst das Darm-Mikrobiom und damit ...
Ernährung beeinflusst Krankheitsrisiko über Darm-Mikrobiom
boerse-global.de, 11.03.26 01:30 Uhr
Darm-Mikrobiom, Mäuse
Eine Studie widerlegt Annahmen zum Mikrobiom: Die Übertragung ...
Darm-Mikrobiom: Ältere Mäuse verjüngen Fruchtbarkeit junger Artgenossen
boerse-global.de, 03.03.26 14:55 Uhr
Darm-Mikrobiom, Studie
Aktuelle Studien zeigen: Kommerzielle Darmflora-Tests liefern ...
Darm-Mikrobiom: Neue Studie warnt vor unzuverlässigen Heimtests
boerse-global.de, 03.03.26 01:30 Uhr
Darm-Mikrobiom, Schlüssel
Neue Forschungsergebnisse belegen dass die Darmflora die ...
Darm-Mikrobiom wird Schlüssel für Krebs-Therapie
boerse-global.de, 26.02.26 03:09 Uhr
Darm-Mikrobiom, Diäten
Forschung zeigt: KI-gestützte individuelle Ernährungspläne ...